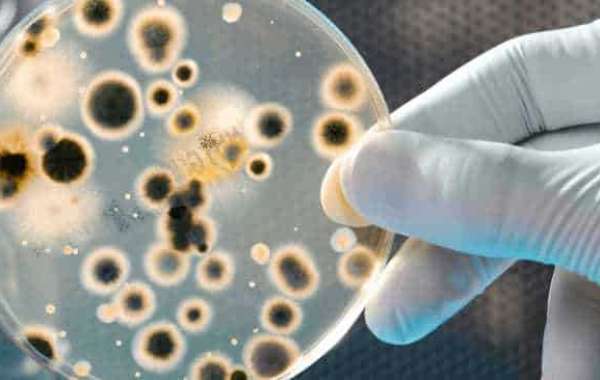

Water Conditioner vs Water Softener: Choose the Eco-Friendly Solution for Your Home | #hard water conditioner uk
Install an Electrolytic Water Conditioner: Say Goodbye to Limescale | #salt free water conditioner uk
Water-Conditioners.co.uk explains how a water conditioner works and the benefits of fitting one in your home. A water conditioner is a great way to protect your boiler and kitchen appliances. It reduces the problems caused by scale build-up in hard water areas. Check our website for more details.